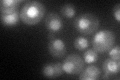
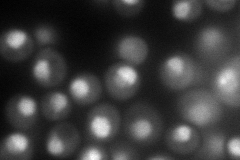
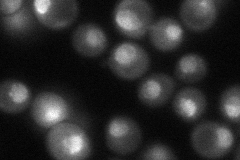

View description
Nuclear envelope protein that mediates the nuclear export of importin alpha (Srp1p), homolog of metazoan CAS protein, required for accurate chromosome segregation
Localization:
Intensity:
Fold change:
Significance:
-
C’ GFP library in SD
nucleus59.88 -
N' NOP1pr-GFP in SD

punctate,nucleus114.677 -
N' TEF2pr-mCherry in SD
nucleus,nucleolus161.057 -
N' NATIVEpr-GFP in SD
punctate,nucleus61.8888 -
N' TEF2pr-VC and Cyto-VN in SD

punctate,nuclear periphery58.1667 -
C’ GFP library in SD+DTT

nucleus46.650.77No -
C’ GFP library in SD+H2O2

nucleus53.510.89No -
C’ GFP library in Starvation Media

nucleus48.240.8No -
C’ GFP library on the background of Pup2-DaMP

nucleus -
C’ GFP library on the background of CCT mutant

nucleus54.02230.902085No
